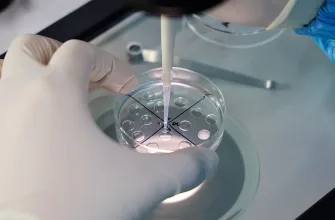

Добавь сайт в закладки нажми CTRL+D
Домашние растения для многих стали не просто украшением интерьера, а настоящими членами семьи, которые могут радовать своим присутствием десятилетиями
Перед тем как принести новое растение в дом, важно не только изучить правила ухода за ним, но и узнать о его энергетическом влиянии. С давних времен известно, что растения способны менять атмосферу в доме и даже влиять на судьбы его обитателей.
Толстянка, или «денежное дерево», известна своей способностью привлекать финансовое благополучие и способствовать карьерному росту. Для усиления этого эффекта при пересадке рекомендуется положить на дно горшка монету, а сам горшок выбрать зеленого, красного или черного цвета. Существует поверье, что если получить отросток «денежного дерева» от успешных и состоятельных людей, то финансовая удача будет более заметной.
«Женское счастье» — так называют спатифиллум не просто так. По народным поверьям, этот цветок помогает одиноким девушкам найти свою любовь, а замужним женщинам — укрепить семейные узы и получить больше внимания от супруга. Особенно сильным считается полив этого растения в «женские дни» — среду, пятницу или субботу. Говорят, что это верный способ привлечь счастливую свадьбу.
Герань, известная также как пеларгония, считается растением с исключительно позитивной энергетикой. Её рекомендуется размещать в спальне, детской или гостиной, чтобы она приносила в дом удачу, мир и благополучие. Считается, что герань помогает успокоить нервы, улучшить качество сна и создать атмосферу уюта и гармонии.
Алоэ, прославленный своими целебными свойствами, также является защитником домашнего очага. Этот неприхотливый цветок оберегает дом от негативной энергии, зависти и недоброжелателей, а также способствует укреплению семейных отношений. Алоэ символизирует здоровье, долголетие и взаимопонимание.
Поделись видео: